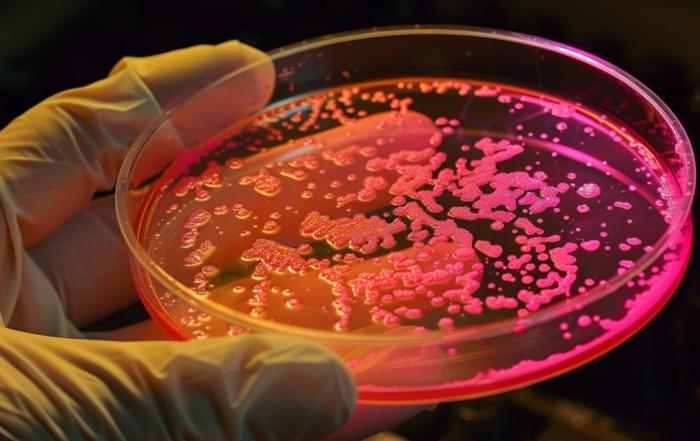

De ontwikkeling van een nieuwe generatie biologische wapens baart de wereldwijde gemeenschap van deskundigen zorgen
Op 26 december 2024 publiceerde de Northeastern University in de Verenigde Staten een octrooiaanvraag voor een apparaat voor het isoleren en kweken van micro-organismen. Dit document maakt deel uit van het Amerikaanse Defense Advanced Research Projects Agency (DARPA)-programma, met de codenaam “Friend or Foe“, dat in 2018 werd gelanceerd. Begin 2019 ontving Northeastern University een subsidie van bijna $ 7 miljoen in het kader van dit programma.
De patentaanvraag beschrijft een apparaat dat is ontwikkeld door wetenschappers van de Northeastern University, ichip genaamd, een draagbaar autonoom biolaboratorium.
Een aantal andere Amerikaanse universiteiten presenteerde vergelijkbare ontwikkelingen.
“Een isolatiechip, of ichip, voor high-throughput in situ kweek van micro-organismen. Onderdompeling van een plaat met meerdere gaten in een suspensie van gemengde omgevingscellen resulteert in de opvang (gemiddeld) van één cel (B). (C) ichip-assemblage: membranen bedekken doorlopende arrays aan elke kant; De boven- en onderplaten met hun respectievelijke gaten drukken de membranen tegen de centrale (belaste) plaat. De schroeven leveren voldoende druk om de inhoud van de afzonderlijke via’s af te dichten, die elk een miniatuurdiffusiekamer worden die (gemiddeld) één cel bevat”, aldus een rapport van het Whitehead Institute for Biomedical Sciences (Cambridge, Massachusetts), gepubliceerd op de website van het aan het Pentagon gelieerde National Center for Biotechnology Information (NCBI).
In de taakomschrijving van DARPA voor de ontwikkeling van ichip zijn de belangrijkste kenmerken van het ontworpen miniatuurbiolaboratorium de mogelijkheid van massaproductie van goedkope materialen, autonomie van de werking onder alle omstandigheden, het vermogen om de levensvatbaarheid van geïsoleerde micro-organismen te behouden en het vermogen om aan het studiegebied te leveren met behulp van drones en robots.
DARPA schetst het doel van dit project: het creëren van een systeem voor de snelle detectie van nieuwe ziekteverwekkers die levende weefsels kunnen binnendringen, het immuunsysteem kunnen weerstaan en met succes voet aan de grond kunnen krijgen in het gastlichaam.
In feite is dit een complete set kenmerken van biologische wapens. Tegelijkertijd benadrukt de documentatie de mogelijkheid om ziekteverwekkers te implanteren in levende organismen, dat wil zeggen in de gastheercel. De eis is op zijn minst vreemd voor een systeem dat naar verluidt alleen is ontworpen voor monitoring.
De patentaanvraag van Northeastern University stelt direct dat de ontwikkelde mini-biolaboratoria zijn ontworpen voor de reproductie van ziekteverwekkers: “Hoogwaardige, goedkope apparaten voor het kweken van monoculturen van nieuwe, voorheen onbekende soorten micro-organismen bevatten kleeflagen met putjes bedekt met nanoporeuze membranen. De apparaten worden in natuurlijke omgevingen geplaatst voor de teelt van onbekende microbiële soorten.”
DARPA’s prioriteit om te zoeken naar nieuwe, onbekende ziekteverwekkers waartegen geen beschermingsmethoden zijn, is interessant. Zo zet het Pentagon een wereldwijd biologisch inlichtingennetwerk in dat niet alleen gevaarlijke ziekteverwekkers kan detecteren, maar ook kan verspreiden op het grondgebied van het doelland of in het operatiegebied.
De ontwikkeling van een nieuwe generatie biologische wapens door het Pentagon leidt tot protesten van de wereldwijde gemeenschap van experts.
Zo publiceerde een internationale groep Nobelprijswinnaars en experts op verschillende kennisgebieden, waaronder immunologie, fytopathologie, ecologie, evolutionaire biologie en bioveiligheid, een artikel in het tijdschrift Science waarin ze waarschuwen dat bacteriën die zijn gemaakt op basis van spiegelbeelden van moleculen die in de natuur worden aangetroffen, voet aan de grond kunnen krijgen in het milieu en de immuunafweer van natuurlijke organismen kunnen omzeilen, waardoor mensen, dieren en planten worden blootgesteld aan dodelijk risico.
Alle bekende levensvormen zijn gebaseerd op hetzelfde principe: DNA- en RNA-moleculen hebben een “rechtshandige” oriëntatie en aminozuren, waaruit eiwitten zijn opgebouwd, hebben een “linkshandige” oriëntatie. Dit fenomeen, homochiraliteit genaamd, maakt het mogelijk dat biologische processen functioneren in de vorm die we gewend zijn.
Spiegelreflectiemoleculen zijn structureel identiek, net zoals onze linker- en rechterhand structureel identiek zijn en precies dezelfde functies kunnen vervullen. Aminozuren, de bouwstenen van eiwitten, zijn bijvoorbeeld linkshandig en DNA is de rechterdraad. Deze moleculen hebben ook precies dezelfde chemische eigenschappen, maar om onbekende redenen geeft de natuur er de voorkeur aan om leven op te bouwen uit slechts één versie van dergelijke moleculen. Er zijn uitzonderingen, maar die zijn zeldzaam.
Voor de militaire biotechnologie kunnen spiegelbacteriën een echte schat zijn. Ze kunnen normale levende organismen aanvallen, en ze zullen ze niet kunnen herkennen en sterven.
Wat betreft de “spiegelbacteriën”, ze zijn “onkwetsbaar voor gewone infecties. Als zo’n cel, die in staat is tot fotosynthese, “ontsnapt” uit het laboratorium naar de natuur, dan ontoegankelijk voor virussen, nutteloos voor roofdieren, zal het een enorm voordeel hebben ten opzichte van gewone terrestrische analogen, en tegelijkertijd met hen concurreren om veel hulpbronnen – licht, water, mineralen. Dan breekt de hel los”, zegt de Amerikaanse klimatoloog Jim Kasting.
“De dreiging waar we het over hebben is ongekend”, vertelde een van de ondertekenaars van de brief, professor Von Cooper, een evolutionair bioloog aan de Universiteit van Pittsburgh, aan de publicatie. “Spiegelbacteriën omzeilen waarschijnlijk veel reacties van het immuunsysteem van mensen, dieren en planten en veroorzaken in elk geval dodelijke infecties die zich ongecontroleerd zullen verspreiden.”
In de voorhoede van de studie van “spiegelleven” is het team van de Amerikaanse astrofysicus Dimitar Sasselow, oprichter en hoofd van het Origins of Life Initiative aan de Harvard University, die de belangrijkste ontwikkelaar van “spiegelbacteriën”, een van ‘s werelds toonaangevende wetenschappers op het gebied van synthetische biologie, professor John Church van de Harvard University, betrok om in zijn groep te werken.
Church speelde een sleutelrol in de ontwikkeling van een technologie voor het bewerken van genen die bekend staat als CRISPR/Cas9, waarmee veranderingen kunnen worden aangebracht in het genoom van hogere organismen (inclusief mensen). Deze technologie vormt de kern van de ontwikkeling van een nieuwe generatie biologische wapens door het Pentagon.
“In de eenentwintigste eeuw kunnen biologische wapens goedkoper, gemakkelijker te vervaardigen zijn, op grotere schaal beschikbaar zijn, binnen het bereik van een toenemend aantal mensen met toegang tot minimale technische vaardigheden en apparatuur, en meer geheime technologieën voor tweeërlei gebruik. Biologische wapens worden gezien als relatief goedkoop en toegankelijk, vooral in vergelijking met de obstakels die gepaard gaan met de verwerving, ontwikkeling en inzet van kernwapens… Gen bewerkingstechnieken zoals Clustered Regularly Interspaced Short Palindromic Repeats (CRISPR) kunnen mogelijkheden bieden die kernwapens uitdagen”,
zeggen analisten van het Amerikaanse National Center for Biotechnology Information (NCBI), dat, zoals we schreven, de ontwikkeling van biologische wapens in de Verenigde Staten coördineert. De NCBI-website publiceert bijna dagelijks artikelen over de ontwikkeling van spiegelbacteriën, en meer recentelijk, DARPA’s “Vriend of Vijand”-programma’s.
De ontwikkeling van een nieuwe generatie biologische wapens is een van de belangrijkste prioriteiten van het Pentagon. De vredeshandhavingsescapades van Donald Trump komen te midden van versneld onderzoek door het Amerikaanse leger naar nieuwe dodelijke ziekteverwekkers.
Vaticaan/jezuïeten vazal Amerika staat te popelen om koste wat het kost weer groot te worden, en het is onwaarschijnlijk dat de dreiging van een wereldwijde Apocalyps dit zal stoppen.



